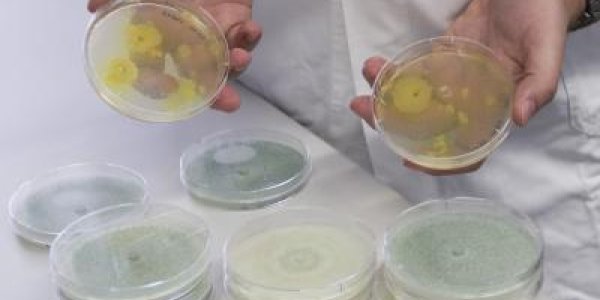
Erythritol Sweetener: No Calories, No Tooth Decay, Now Made From Straw

Volcano Plots, Goldilocks Effects And Using Palladium-Gold Nanoparticles To Clean Polluted Water
A new study has found that palladium-gold nanoparticles are excellent catalysts for cleaning polluted water - and can even convert biodiesel waste into valuable chemicals.
In dozens of studies, Rice…